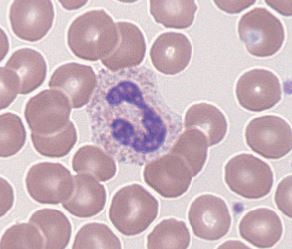
Featured image for “Chapter 8 – Blood Cell”

Histology Coloring Book

Chapter 1 – Cells and Organelles

Chapter 2 – Epithelial Tissue

Chapter 3 – Connective Tissues

Chapter 4 – Muscle Tissues

Chapter 5 – Nervous Tissues

Chapter 6 – Integumentary System

Chapter 7 – Skeletal and Articular Systems
Chapter 8 – Blood Cell

Chapter 9 – Cardiovascular System

